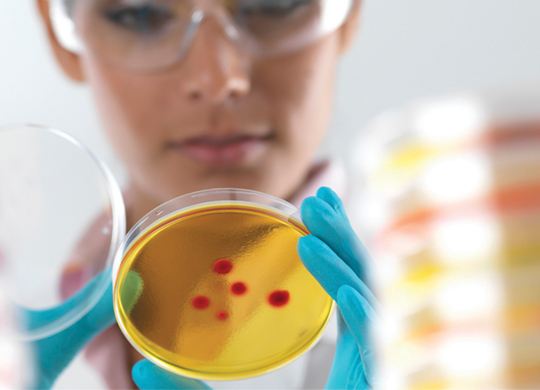
Yellowcloning.jpg Yellowcloning.jpg

Cloning
Featured Solutions
Discover Agilent’s comprehensive collection of innovative molecular biology products. The SureVector cloning system enables the rapid and reliable assembly of custom cloning and expression vectors. The extensive line of competent cell strains provide the highest transformation efficiencies available.